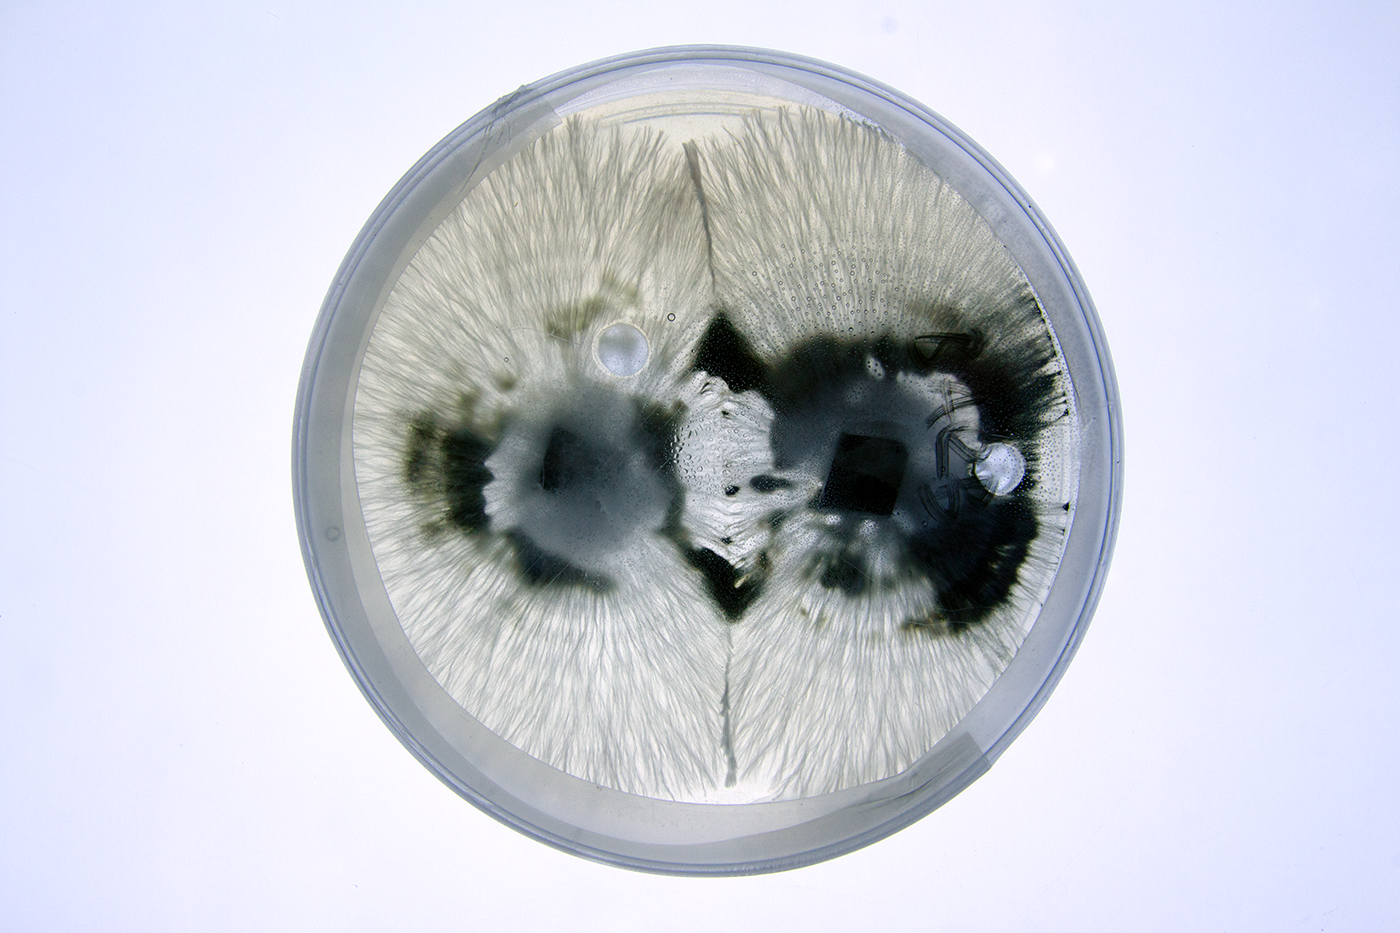
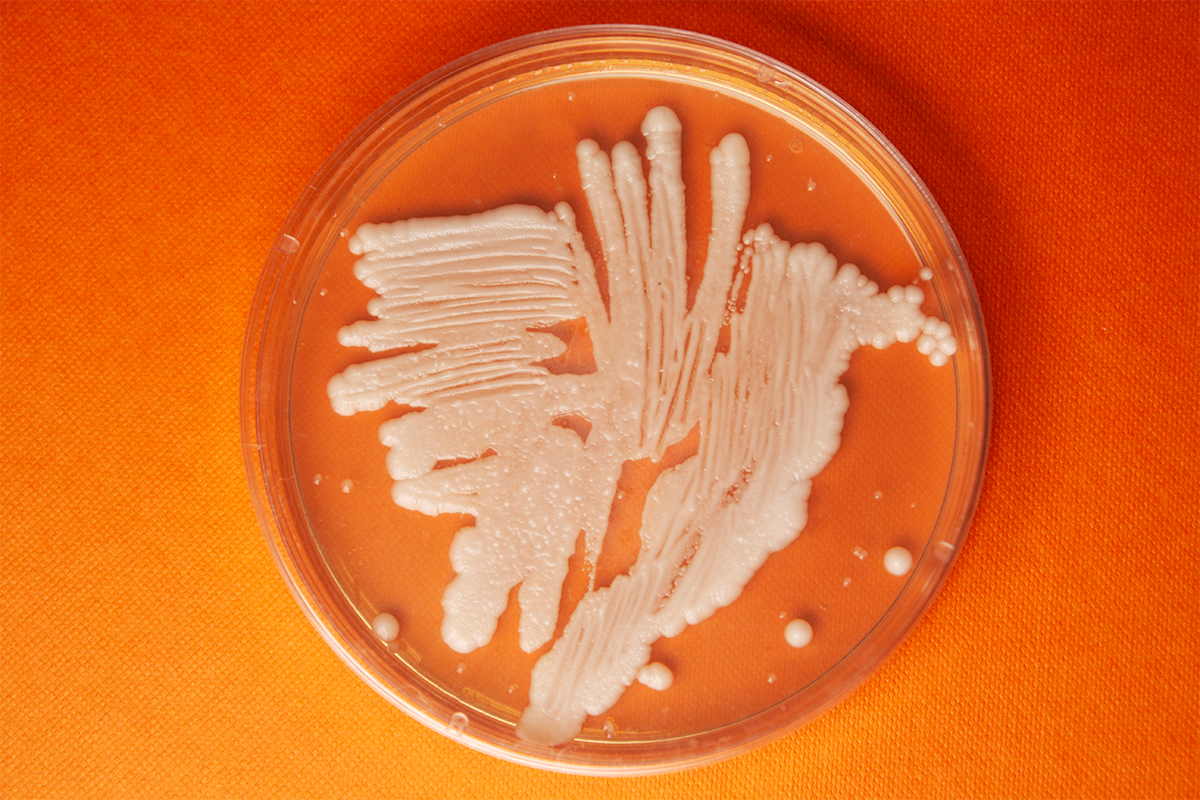

FILM PHOTOGRAPHY

2016-2023
︎
